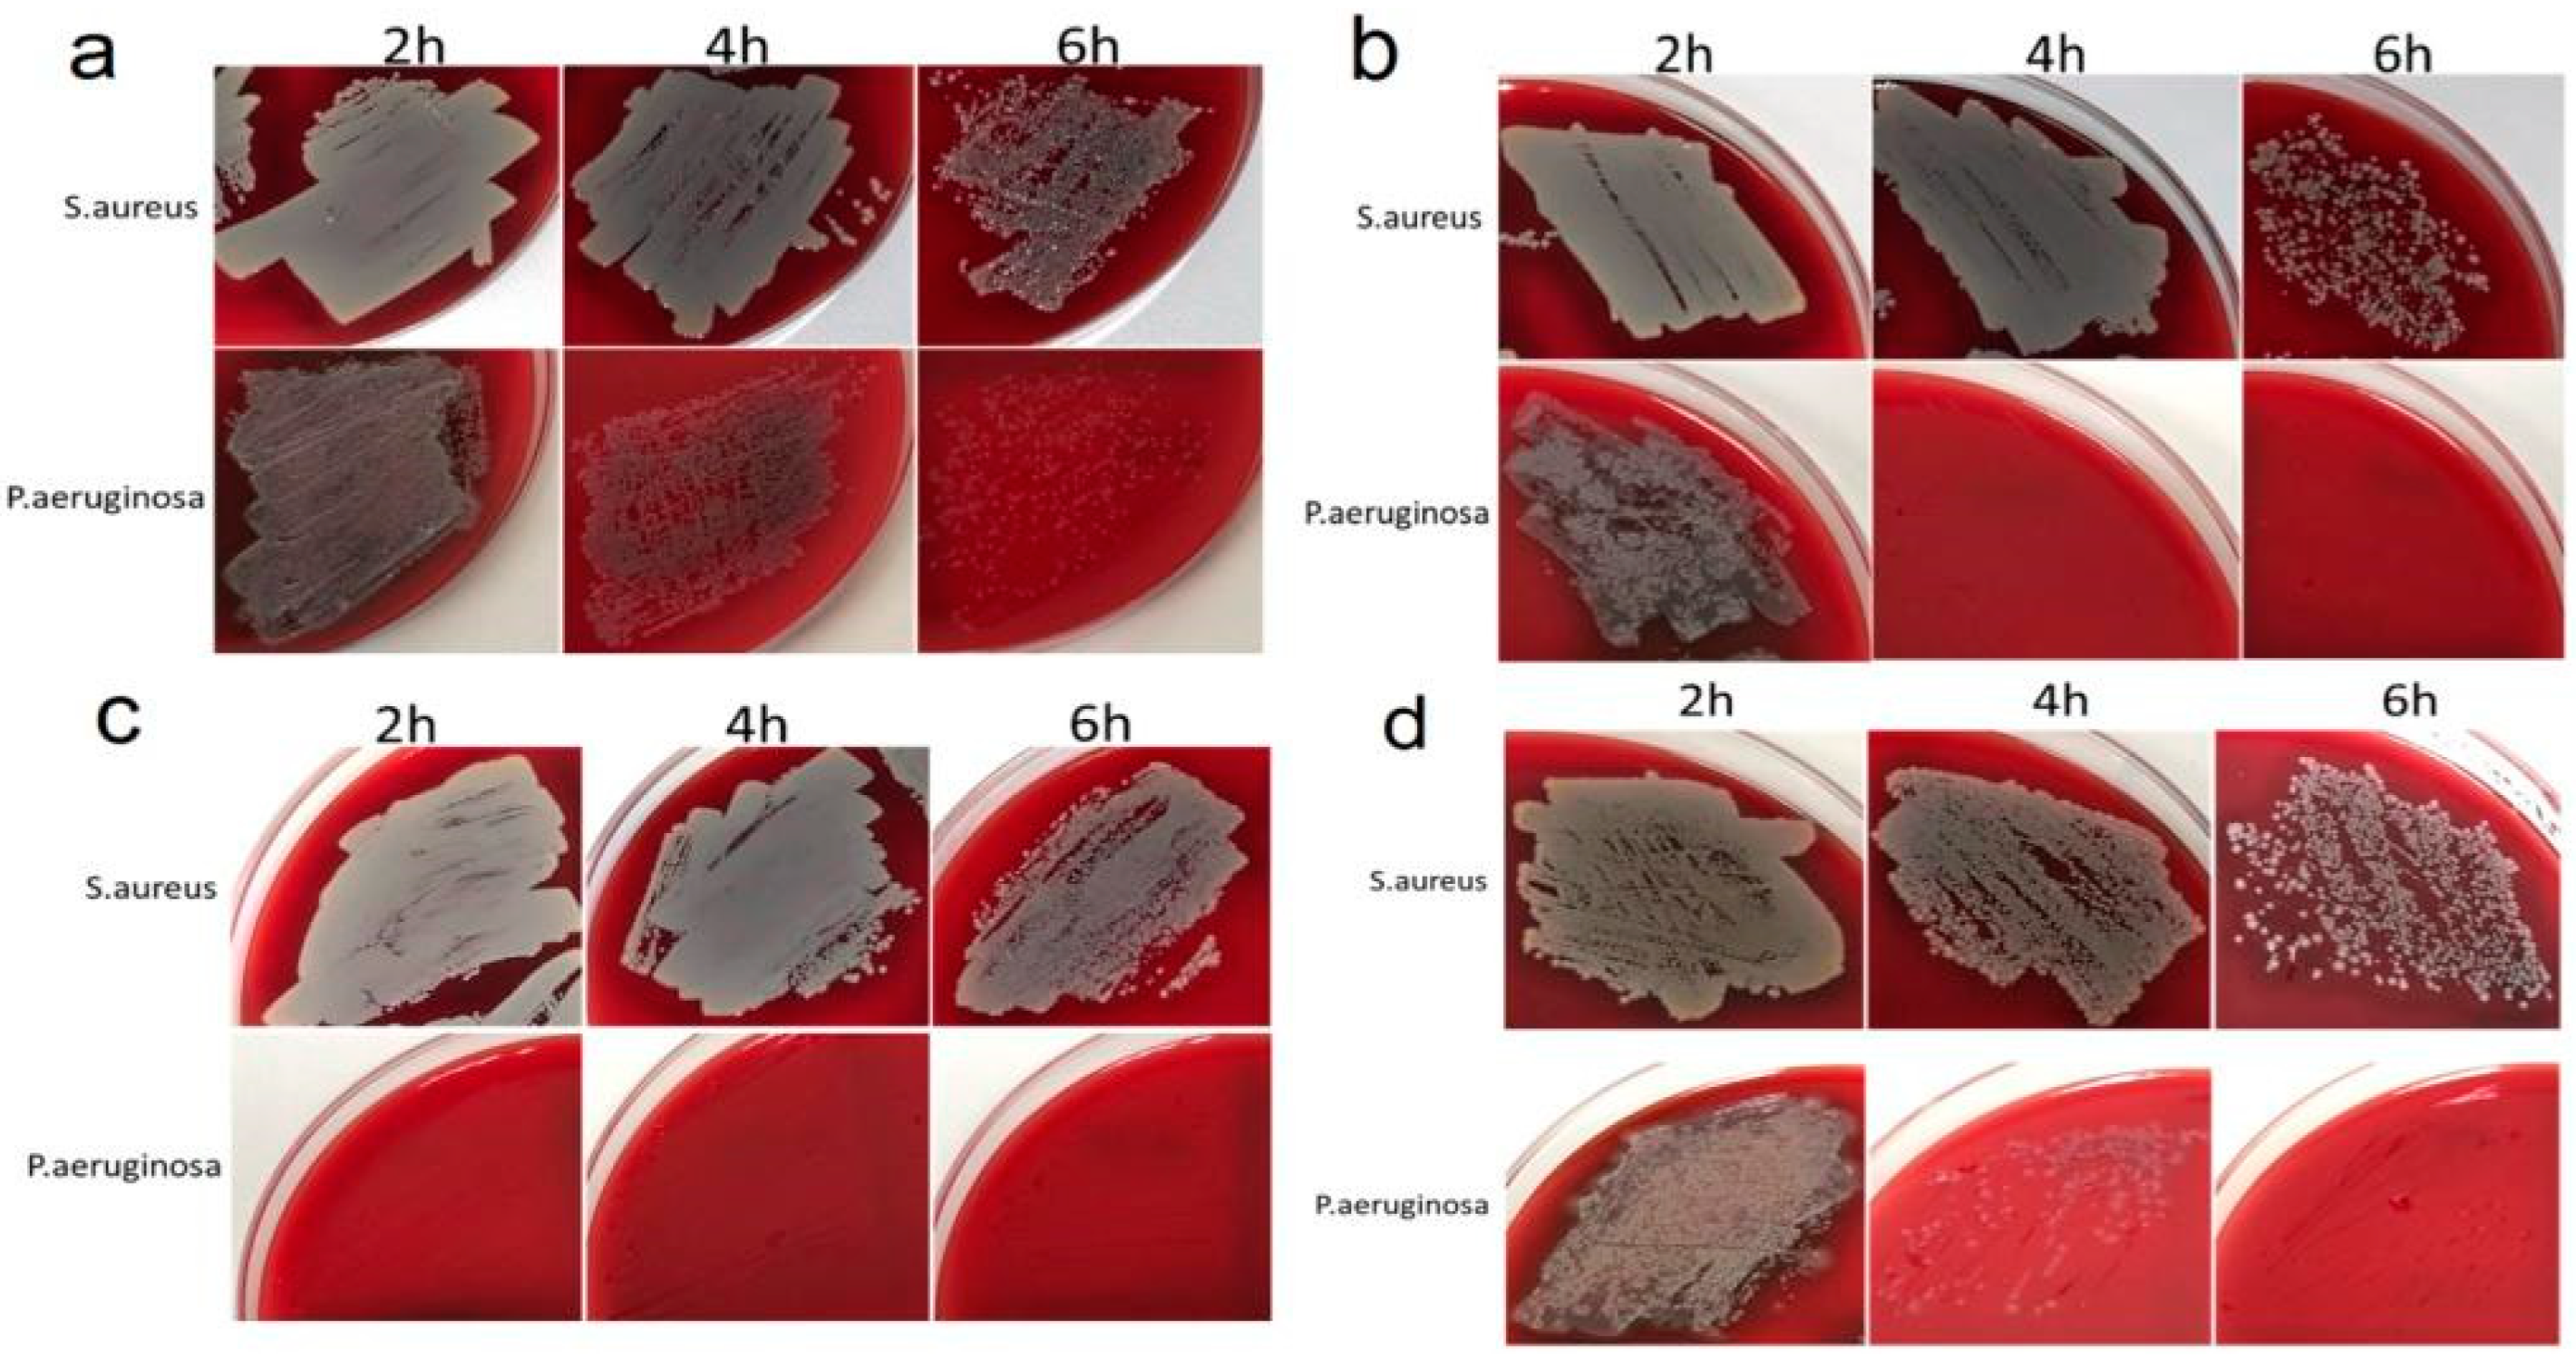
Ijms 25 01100 g007 Ijms 25 01100 g007

Vapor-Phase-Deposited Ag/Ir and Ag/Au Film Heterostructures for Implant Materials: Cytotoxic, Antibacterial and Histological Studies
Abstract
1. Introduction
2. Results
- “Ti” carriers: pristine Ti6Al4V discs; according to atomic force microscopy (AFM) data, the average roughness (Ra) is 30 nm (Figure 1a);
- “Ti*” carriers: surface-polished Ti6Al4V discs; according to AFM data, the ordered grooved altitude differences are up to 300 nm whereas Ra is 60 nm (Figure 1b);
- “CFR-PEEK” carriers: polyetheretherketone discs reinforced with carbon fiber (30%); according to AFM data, Ra is 55 nm.
2.1. Deposition and Characterization of Ir and Au Sublayers
2.2. Deposition and Characterization of Ag/Ir and Ag/Au Heterostructures
2.2.1. Ag/Ir and Ag/Au Heterostructures Obtained via the PVD Method
2.2.2. Ag/Ir and Ag/Au Heterostructures Obtained via MOCVD
2.3. Biological Studies
2.3.1. Antibacterial Activity
2.3.2. Cell Viability
2.3.3. In Vivo Biocompatibility
3. Discussion
3.1. Film Heterostructures: Active Component Formation
3.2. Antibacterial Activity
3.3. In Vivo and In Vitro Biocompatibility
4. Materials and Methods
4.1. Materials
4.2. Preparation of Ir, Au Layers and Ag/Ir, Ag/Au Heterostuctures
4.3. Methods
4.4. Biological Studies
4.4.1. Antibacterial Activity Test
4.4.2. Cytotoxicity via the XTT Test
4.4.3. Subcutaneous Implantation in Animals
4.4.4. Histological Test
5. Conclusions
Supplementary Materials
Author Contributions
Funding
Institutional Review Board Statement
Informed Consent Statement
Data Availability Statement
Acknowledgments
Conflicts of Interest
References
- Mlalila, N.; Swai, H.; Hilonga, A.; Kadam, D. Antimicrobial dependence of silver nanoparticles on surface plasmon resonance bands against Escherichia coli. Nanotechnol. Sci. Appl. 2016, 10, 1–9. [Google Scholar] [CrossRef] [PubMed]
- Arango, S.; Peláez-Vargas, A.; García, C. Coating and Surface Treatments on Orthodontic Metallic Materials. Coatings 2012, 3, 1–15. [Google Scholar] [CrossRef]
- Henderson, E.R.; Groundland, J.S.; Pala, E.; Dennis, J.A.; Wooten, R.; Cheong, D.; Windhager, R.; Kotz, R.I.; Mercuri, M.; Funovics, P.T.; et al. Failure mode classification for tumor endoprostheses: Retrospective review of five institutions and a literature review. J. Bone Jt. Surg. Am. 2011, 93, 418–429. [Google Scholar] [CrossRef]
- Yan, Y.; Orlandi, M.; Suvan, J.; Harden, S.; Smith, J.; D’Aiuto, F. Association between peri-implantitis and systemic inflammation: A systematic review. Front. Immunol. 2023, 14, 1235155. [Google Scholar] [CrossRef]
- Basova, T.V.; Vikulova, E.S.; Dorovskikh, S.I.; Hassan, A.; Morozova, N.B. The use of noble metal coatings and nanoparticles for the modification of medical implant materials. Mater. Des. 2021, 204, 109672. [Google Scholar] [CrossRef]
- Wan, Y.Z.; Raman, S.; He, F.; Huang, Y. Surface modification of medical metals by ion implantation of silver and copper. Vacuum 2007, 81, 1114–1118. [Google Scholar] [CrossRef]
- Knetsch, M.L.W.; Koole, L.H. New strategies in the development of antimicrobial coatings: The example of increasing usage of silver and silver nanoparticles. Polymers 2011, 3, 340–366. [Google Scholar] [CrossRef]
- Marambio-Jones, C.; Hoek, E.M.V. A review of the antibacterial effects of silver nanomaterials and potential implications for human health and the environment. J. Nanopart. Res. 2010, 12, 1531–1551. [Google Scholar] [CrossRef]
- Raza, M.; Kanwal, Z.; Rauf, A.; Sabri, A.; Riaz, S.; Naseem, S. Size- and Shape-Dependent Antibacterial Studies of Silver Nanoparticles Synthesized by Wet Chemical Routes. Nanomaterials 2016, 6, 74. [Google Scholar] [CrossRef]
- Ferraris, S.; Spriano, S. Antibacterial titanium surfaces for medical implants. Mater. Sci. Eng. C 2016, 61, 965–978. [Google Scholar] [CrossRef]
- Bonilla-Gameros, L.; Chevallier, P.; Sarkissian, A.; Mantovani, D. Silver-based antibacterial strategies for healthcare-associated infections: Processes, challenges, and regulations. An integrated review. Nanomedicine 2020, 24, 102142. [Google Scholar] [CrossRef] [PubMed]
- Piszczek, P.; Radtke, A. Silver Nanoparticles Fabricated Using Chemical Vapor Deposition and Atomic Layer Deposition Techniques: Properties, Applications and Perspectives: Review. In Noble and Precious Metals—Properties, Nanoscale Effects and Applications; Seehra, M.S., Bristow, A.D., Eds.; InTech: Rijeka, Croatia, 2018; pp. 187–213. ISBN 978-1-78923-293-6. [Google Scholar]
- Draviana, H.T.; Fitriannisa, I.; Khafid, M.; Krisnawati, D.I.; Widodo; Lai, C.H.; Fan, Y.J.; Kuo, T.R. Size and charge effects of metal nanoclusters on antibacterial mechanisms. J. Nanobiotechnol. 2023, 21, 428. [Google Scholar] [CrossRef]
- Scholz, M.-S.; Blanchfield, J.P.; Bloom, L.D.; Coburn, B.H.; Elkington, M.; Fuller, J.D.; Gilbert, M.E.; Muflahi, S.A.; Pernice, M.F.; Rae, S.I.; et al. The use of composite materials in modern orthopaedic medicine and prosthetic devices: A review. Compos. Sci. Technol. 2011, 71, 1791–1803. [Google Scholar] [CrossRef]
- Chernousova, S.; Epple, M. Silver as antibacterial agent: Ion, nanoparticle, and metal. Angew. Chem. Int. Ed. Engl. 2013, 52, 1636–1653. [Google Scholar] [CrossRef]
- Kumar, R.; Münstedt, H. Silver ion release from antimicrobial polyamide/silver composites. Biomaterials 2005, 26, 2081–2088. [Google Scholar] [CrossRef] [PubMed]
- Guo, Z.; Chen, C.; Gao, Q.; Li, Y.; Zhang, L. Fabrication of silver-incorporated TiO2 nanotubes and evaluation on its antibacterial activity. Mater. Lett. 2014, 137, 464–467. [Google Scholar] [CrossRef]
- Roguska, A.; Pisarek, M.; Andrzejczuk, M.; Lewandowska, M.; Kurzydlowski, K.J.; Janik-Czachor, M. Surface characterization of Ca-P/Ag/TiO2 nanotube composite layers on Ti intended for biomedical applications. J. Biomed. Mater. Res. Part A 2012, 100A, 1954–1962. [Google Scholar] [CrossRef]
- Brennan, S.A.; Ní Fhoghlú, C.; Devitt, B.M.; O’Mahony, F.J.; Brabazon, D.; Walsh, A. Silver nanoparticles and their orthopaedic applications. Bone Jt. J. 2015, 97-B, 582–589. [Google Scholar] [CrossRef]
- Zhao, C.; Feng, B.; Li, Y.; Tan, J.; Lu, X.; Weng, J. Preparation and antibacterial activity of titanium nanotubes loaded with Ag nanoparticles in the dark and under the UV light. Appl. Surf. Sci. 2013, 280, 8–14. [Google Scholar] [CrossRef]
- Naidu, K.S.B.; Adam, J.K.; Govender, P. Biomedical applications and toxicity of nanosilver: A review. Med. Technol. SA 2015, 29, 13–19. [Google Scholar]
- Miyazawa, N.; Hakamada, M.; Mabuchi, M. Antimicrobial mechanisms due to hyperpolarisation induced by nanoporous Au. Sci. Rep. 2018, 8, 3870. [Google Scholar] [CrossRef] [PubMed]
- Köller, M.; Bellova, P.; Javid, S.M.; Motemani, Y.; Khare, C.; Sengstock, C.; Tschulik, K.; Schildhauer, T.A.; Ludwig, A. Antibacterial activity of microstructured sacrificial anode thin films by combination of silver with platinum group elements (platinum, palladium, iridium). Mater. Sci. Eng. C 2017, 74, 536–541. [Google Scholar] [CrossRef] [PubMed]
- Dorovskikh, S.I.; Vikulova, E.S.; Sergeevichev, D.S.; Guselnikova, T.Y.; Zheravin, A.A.; Nasimov, D.A.; Vasilieva, M.B.; Chepeleva, E.V.; Saprykin, A.I.; Basova, T.V.; et al. Biological Studies of New Implant Materials Based on Carbon and Polymer Carriers with Film Heterostructures Containing Noble Metals. Biomedicines 2022, 10, 2230. [Google Scholar] [CrossRef] [PubMed]
- Dorovskikh, S.I.; Vikulova, E.S.; Chepeleva, E.V.; Vasilieva, M.B.; Nasimov, D.A.; Maksimovskii, E.A.; Tsygankova, A.R.; Basova, T.V.; Sergeevichev, D.S.; Morozova, N.B. Noble Metals for Modern Implant Materials: MOCVD of Film Structures and Cytotoxical, Antibacterial, and Histological Studies. Biomedicines 2021, 9, 851. [Google Scholar] [CrossRef] [PubMed]
- Dorovskikh, S.; Vikulova, E.; Sergeevichev, D.; Guselnikova, T.; Korolkov, I.; Fedorenko, A.; Nasimov, D.; Vasilieva, M.; Chepeleva, E.; Zherikova, K.; et al. Heterostructures Based on Noble Metal Films with Ag and Au Nanoparticles: Fabrication, Study of In Vivo Biocompatibility and Antibacterial Activity. Coatings 2023, 13, 1269. [Google Scholar] [CrossRef]
- Köller, M.; Sengstock, C.; Motemani, Y.; Khare, C.; Buenconsejo, P.J.S.; Geukes, J.; Schildhauer, T.A.; Ludwig, A. Antibacterial activity of microstructured Ag/Au sacrificial anode thin films. Mater. Sci. Eng. C 2015, 46, 276–280. [Google Scholar] [CrossRef]
- Santos, P.A.; Rocha, C.S.; Baptista, M.S. Adhesion and proliferation of HeLa and fibroblast cells on chemically-modified gold surfaces. Colloids Surf. B Biointerfaces 2014, 123, 429–438. [Google Scholar] [CrossRef]
- Rebollar, E.; Sanz, M.; Esteves, C.; Martínez, N.F.; Ahumada, Ó.; Castillejo, M. Gold coating of micromechanical DNA biosensors by pulsed laser deposition. J. Appl. Phys. 2012, 112, 084330. [Google Scholar] [CrossRef]
- Sanyal, M.; Datta, A.; Hazra, S. Morphology of nanostructured materials. Pure Appl. Chem. 2002, 74, 1553. [Google Scholar] [CrossRef]
- Huy, T.; Quy, N.; Le, A.-T. Silver nanoparticles: Synthesis, properties, toxicology, applications and perspectives. Adv. Nat. Sci. Nanosci. Nanotechnol. 2013, 4, 33001. [Google Scholar] [CrossRef]
- Campbell, C.T. Ultrathin metal films and particles on oxide surfaces: Structural, electronic and chemisorptive properties. Surf. Sci. Rep. 1997, 27, 1–111. [Google Scholar] [CrossRef]
- Vikulova, E.S.; Karakovskaya, K.I.; Korolkov, I.V.; Koretskaya, T.P.; Chepeleva, E.V.; Kuz’min, N.B.; Fedorenko, A.D.; Pischur, D.P.; Guselnikova, T.Y.; Maksimovskii, E.A.; et al. Application of Biocompatible Noble Metal Film Materials to Medical Implants: TiNi Surface Modification. Coatings 2023, 13, 222. [Google Scholar] [CrossRef]
- Krishnamurthy, S.; Esterle, A.; Sharma, N.C.; Sahi, S.V. Yucca-derived synthesis of gold nanomaterial and their catalytic potential. Nanoscale Res. Lett. 2014, 9, 627. [Google Scholar] [CrossRef] [PubMed]
- Han, M.K.; Im, J.B.; Hwang, M.J.; Kim, B.J.; Kim, H.Y.; Park, Y.J. Effect of indium content on the microstructure, mechanical properties and corrosion behavior of titanium alloys. Metals 2015, 5, 850–862. [Google Scholar] [CrossRef]
- Doumeng, M.; Makhlouf, L.; Berthet, F.; Marsan, O.; Delbé, K.; Denape, J.; Chabert, F. A comparative study of the crystallinity of polyetheretherketone by using density, DSC, XRD, and Raman spectroscopy techniques. Polym. Test. 2021, 93, 106878. [Google Scholar] [CrossRef]
- Zamchiy, A.O.; Baranov, E.A.; Konstantinov, V.O.; Lunev, N.A.; Sakhapov, S.Z.; Korolkov, I.V.; Volodin, V.A. Activation energy of gold-induced crystallization of amorphous silicon suboxide films. Mater. Lett. 2022, 323, 132566. [Google Scholar] [CrossRef]
- Oliveira, W.F.; Silva, P.M.S.; Silva, R.C.S.; Silva, G.M.M.; Machado, G.; Coelho, L.C.B.B.; Correia, M.T.S. Staphylococcus aureus and Staphylococcus epidermidis infections on implants. J. Hosp. Infect. 2018, 98, 111–117. [Google Scholar] [CrossRef]
- Paprocka, P.; Durnaś, B.; Mańkowska, A.; Król, G.; Wollny, T.; Bucki, R. Pseudomonas aeruginosa Infections in Cancer Patients. Pathogens 2022, 11, 679. [Google Scholar] [CrossRef]
- Shareena Dasari, T.P.; Zhang, Y.; Yu, H. Antibacterial Activity and Cytotoxicity of Gold (I) and (III) Ions and Gold Nanoparticles. Biochem. Pharmacol. Open Access 2015, 4, 199. [Google Scholar] [CrossRef]
- Nguyen, N.P.U.; Dang, N.T.; Doan, L.; Nguyen, T.T.H. Synthesis of Silver Nanoparticles: From Conventional to ‘Modern’ Methods—A Review. Processes 2023, 11, 2617. [Google Scholar] [CrossRef]
- Shakir, S.; Saravanan, J.; Rizan, N.; Babu, K.J.; Aziz, M.A.; Moi, P.S.; Periasamy, V.; Kumar, G.G. Fabrication of capillary force induced DNA template Ag nanopatterns for sensitive and selective enzyme-free glucose sensors. Sens. Actuators B Chem. 2018, 256, 820–827. [Google Scholar] [CrossRef]
- Kirubaharan, C.J.; Kalpana, D.; Lee, Y.S.; Kim, A.R.; Yoo, D.J.; Nahm, K.S.; Kumar, G.G. Biomediated Silver Nanoparticles for the Highly Selective Copper(II) Ion Sensor Applications. Ind. Eng. Chem. Res. 2012, 51, 7441–7446. [Google Scholar] [CrossRef]
- Comstock, D.J.; Christensen, S.T.; Elam, J.W.; Pellin, M.J.; Hersam, M.C. Tuning the composition and nanostructure of Pt/Ir films via anodized aluminum oxide templated atomic layer deposition. Adv. Funct. Mater. 2010, 20, 3099–3105. [Google Scholar] [CrossRef]
- Kumar, T.R.; Kumar, G.G.; Manthiram, A. Biomass-Derived 3D Carbon Aerogel with Carbon Shell-Confined Binary Metallic Nanoparticles in CNTs as an Efficient Electrocatalyst for Microfluidic Direct Ethylene Glycol Fuel Cells. Adv. Energy Mater. 2019, 9, 1803238. [Google Scholar] [CrossRef]
- Velmurugan, N.; Kumar, G.G.; Han, S.S.; Nahm, K.S.; Lee, Y.S. Synthesis and Characterization of Potential Fungicidal Silver Nano-sized Particles and Chitosan Membrane Containing Silver Particles. Iran. Polym. J. 2009, 18, 383–392. [Google Scholar]
- Pimpinelli, A.; Villain, J. Physics of Crystal Growth; AA(Universite de Clermont-Ferrand II (Universite Blaise Pascal), France), AB(Centre Commissariat a l’Energie Atomique (CEA), Grenoble); Wob: Worthing, UK, 1999. [Google Scholar]
- Baletto, F.; Mottet, C.; Ferrando, R. Molecular dynamics simulations of surface diffusion and growth on silver and gold clusters. Surf. Sci. 2000, 446, 31–45. [Google Scholar] [CrossRef]
- Kaskow, I.; Decyk, P.; Sobczak, I. The effect of copper and silver on the properties of Au-ZnO catalyst and its activity in glycerol oxidation. Appl. Surf. Sci. 2018, 444, 197–207. [Google Scholar] [CrossRef]
- Gudkov, S.V.; Li, R.; Serov, D.A.; Burmistrov, D.E.; Baimler, I.V.; Baryshev, A.S.; Simakin, A.V.; Uvarov, O.V.; Astashev, M.E.; Nefedova, N.B.; et al. Fluoroplast Doped by Ag2O Nanoparticles as New Repairing Non-Cytotoxic Antibacterial Coating for Meat Industry. Int. J. Mol. Sci. 2023, 24, 869. [Google Scholar] [CrossRef]
- Gudkov, S.V.; Serov, D.A.; Astashev, M.E.; Semenova, A.A.; Lisitsyn, A.B. Ag2O Nanoparticles as a Candidate for Antimicrobial Compounds of the New Generation. Pharmaceuticals 2022, 15, 968. [Google Scholar] [CrossRef] [PubMed]
- Ghotekar, S.; Dabhane, H.; Pansambal, S.; Oza, R.; Tambade, P.; Medhane, V. A Review on Biomimetic Synthesis of Ag2O Nanoparticles using Plant Extract, Characterization and its Recent Applications. Adv. J. Chem. B Nat. Prod. Med. Chem. 2020, 2, 102–111. [Google Scholar] [CrossRef]
- Sangappa, M.; Thiagarajan, P. Combating drug resistant pathogenic bacteria isolated from clinical infections, with silver oxide nanoparticles. Indian J. Pharm. Sci. 2015, 77, 151–155. [Google Scholar] [CrossRef]
- Muhammad, S.; Ali, A.; Zahoor, S.; Xinghua, X.; Shah, J.; Hamza, M.; Kashif, M.; Khan, S.; Khan, B.; Ajat Khel, B.K.; et al. Synthesis of Silver Oxide Nanoparticles and its Antimicrobial, Anticancer, Anti-inflammatory, Wound Healing, and Immunomodulatory Activities—A Review. Acta Sci. Appl. Phys. 2023, 3, 33–48. [Google Scholar]
- Torabi, S.; Mansoorkhani, M.J.K.; Majedi, A.; Motevalli, S. REVIEW: Synthesis, Medical And Photocatalyst Applications of Nano-Ag2O. J. Coord. Chem. 2020, 73, 1861–1880. [Google Scholar] [CrossRef]
- Gomaa, E.Z. Silver nanoparticles as an antimicrobial agent: A case study on Staphylococcus aureus and Escherichia coli as models for Gram-positive and Gram-negative bacteria. J. Gen. Appl. Microbiol. 2017, 63, 36–43. [Google Scholar] [CrossRef] [PubMed]
- Ocsoy, I.; Paret, M.L.; Ocsoy, M.A.; Kunwar, S.; Chen, T.; You, M.; Tan, W. Nanotechnology in Plant Disease Management: DNA-Directed Silver Nanoparticles on Graphene Oxide as an Antibacterial against Xanthomonas perforans. ACS Nano 2013, 7, 8972–8980. [Google Scholar] [CrossRef] [PubMed]
- Bruskov, V.I.; Karp, O.E.; Garmash, S.A.; Shtarkman, I.N.; Chernikov, A.V.; Gudkov, S.V. Prolongation of oxidative stress by long-lived reactive protein species induced by X-ray radiation and their genotoxic action. Free Radic. Res. 2012, 46, 1280–1290. [Google Scholar] [CrossRef] [PubMed]
- Gunawan, C.; Faiz, M.B.; Mann, R.; Ting, S.R.S.; Sotiriou, G.A.; Marquis, C.P.; Amal, R. Nanosilver Targets the Bacterial Cell Envelope: The Link with Generation of Reactive Oxygen Radicals. ACS Appl. Mater. Interfaces 2020, 12, 5557–5568. [Google Scholar] [CrossRef]
- Al Hagbani, T.; Rizvi, S.; Hussain, T.; Mehmood, K.; Rafi, Z.; Moin, A.; Abu Lila, A.; Alshammari, F.; Khafagy, E.-S.; Rahamathulla, M.; et al. Cefotaxime Mediated Synthesis of Gold Nanoparticles: Characterization and Antibacterial Activity. Polymer 2022, 14, 771. [Google Scholar] [CrossRef]
- Grade, S.; Eberhard, J.; Jakobi, J.; Winkel, A.; Stiesch, M.; Barcikowski, S. Alloying colloidal silver nanoparticles with gold disproportionally controls antibacterial and toxic effects. Gold Bull. 2014, 47, 83–93. [Google Scholar] [CrossRef]
- Tiedemann, D.; Taylor, U.; Rehbock, C.; Jakobi, J.; Klein, S.; Kues, W.A.; Barcikowski, S.; Rath, D. Reprotoxicity of gold, silver, and gold–silver alloy nanoparticles on mammalian gametes. Analyst 2014, 139, 931–942. [Google Scholar] [CrossRef]
- Alissawi, N.; Zaporojtchenko, V.; Strunskus, T.; Kocabas, I.; Chakravadhanula, V.S.K.; Kienle, L.; Garbe-Schönberg, D.; Faupel, F. Effect of gold alloying on stability of silver nanoparticles and control of silver ion release from vapor-deposited Ag–Au/polytetrafluoroethylene nanocomposites. Gold Bull. 2013, 46, 3–11. [Google Scholar] [CrossRef]
- Paasche, G.; Ceschi, P.; Löbler, M.; Rösl, C.; Gomes, P.; Hahn, A.; Rohm, H.W.; Sternberg, K.; Lenarz, T.; Schmitz, K.-P.; et al. Effects of metal ions on fibroblasts and spiral ganglion cells. J. Neurosci. Res. 2011, 89, 611–617. [Google Scholar] [CrossRef]
- Xu, Y.; Zheng, B.; He, J.; Cui, Z.; Liu, Y. Silver nanoparticles promote osteogenic differentiation of human periodontal ligament fibroblasts by regulating the RhoA–TAZ axis. Cell Biol. Int. 2019, 43, 910–920. [Google Scholar] [CrossRef] [PubMed]
- Du, J.; Liu, X.; Wong, C.W.Y.; Lok, C.-N.; Yang, Z.; Yuan, Z.; Wong, K.K.Y. Silver nanoparticles promote osteogenic differentiation of mouse embryonic fibroblasts in vitro. Am. J. Stem Cells 2023, 12, 51–59. [Google Scholar]
- You, C.; Zhu, Z.; Wang, S.; Wang, X.; Han, C.; Shao, H. Nanosilver alleviates foreign body reaction and facilitates wound repair by regulating macrophage polarization. J. Zhejiang Univ. B 2023, 24, 510–523. [Google Scholar] [CrossRef]
- Aoyagi, H.; Iwasaki, S. Long-term Effect of Silver Powder in vivo. Dent. Mater. J. 2008, 27, 612–625. [Google Scholar] [CrossRef] [PubMed][Green Version]
- Leonetti, S.; Tuvo, B.; Campanella, B.; Legnaioli, S.; Onor, M.; Bramanti, E.; Totaro, M.; Baggiani, A.; Giorgi, S.; Privitera, G.P.; et al. Evaluation of Microbial Adhesion and Biofilm Formation on Nano-Structured and Nano-Coated Ortho-Prosthetic Materials by a Dynamic Model. Int. J. Environ. Res. Public Health 2020, 17, 1013. [Google Scholar] [CrossRef] [PubMed]
- Zhang, Y.; Zheng, Z.; Yu, M.; Hsu, C.; Berthiaume, E.A.; Pan, H.; Zhang, X.; Stieg, A.Z.; Wu, B.; Wang, H.; et al. Using an Engineered Galvanic Redox System to Generate Positive Surface Potentials that Promote Osteogenic Functions. ACS Appl. Mater. Interfaces 2018, 10, 15449–15460. [Google Scholar] [CrossRef]
- Karakovskaya, K.I.; Dorovskikh, S.I.; Vikulova, E.S.; Ilyin, I.Y.; Zherikova, K.V.; Basova, T.V.; Morozova, N.B. Volatile Iridium and Platinum MOCVD Precursors: Chemistry, Thermal Properties, Materials and Prospects for Their Application in Medicine. Coatings 2021, 11, 78. [Google Scholar] [CrossRef]
- Black, K.; Singh, J.; Mehta, D.; Sung, S.; Sutcliffe, C.J.; Chalker, P.R. Silver Ink Formulations for Sinter-free Printing of Conductive Films. Sci. Rep. 2016, 6, 20814. [Google Scholar] [CrossRef]
- Pfeifer, V.; Jones, T.E.; Velasco Vélez, J.J.; Massué, C.; Greiner, M.T.; Arrigo, R.; Teschner, D.; Girgsdies, F.; Scherzer, M.; Allan, J.; et al. The electronic structure of iridium oxide electrodes active in water splitting. Phys. Chem. Chem. Phys. 2016, 18, 2292–2296. [Google Scholar] [CrossRef] [PubMed]

| Sample | Implantation Time (Days) | Packing Density | Microvessels | Macrophages | Lymphocytes | FBCs | Mast Cells |
|---|---|---|---|---|---|---|---|
| Ag/Ir/Ti | 30 | 1–2 | 1 | 1 | 0 | 0 | 0 |
| 90 | 1 | 1 | 1 | 0 | 0 | 0 | |
| Ag/Ir/Ti* | 30 | 0–1 | 1 | 0 | 0 | 0 | 0 |
| 90 | 2–3 | 1 | 2–3 | 0 | 0 | 0 | |
| Ag/Au/Ti | 30 | 2 | 1 | 0 | 0 | 0 | 0 |
| 90 | 1–2 | 0 | 0 | 0 | 0 | 0 | |
| Ag/Au/CFR-PEEK | 30 | 0–1 | 1 | 0 | 0 | 0 | 0 |
| 90 | 1–2 | 2 | 1 | 0 | 0 | 0 | |
| Ag/Ir/CFR-PEEK | 30 | 1–2 | 1 | 0 | 0 | 0 | 0 |
| 90 | 1 | 1 | 1 | 0 | 0 | 0 |
| Sample | Initial Ag Content (μg/cm2) | Implantation Time (30 Days) | Implantation Time (90 Days) |
|---|---|---|---|
| Ag/Au/CFR-PEEK | 13.2 ± 1.3 | 1.8 ± 0.1 | 0.89 ± 0.08 |
| Ag/Ir/CFR-PEEK | 13.5 ± 1.3 | 1.4 ± 0.1 | 0.89 ± 0.08 |
| Ag/Ir/Ti | 15.7 ± 1.5 | 5.2 ± 0.2 | 2.6 ± 0.1 |
| Ag/Ir/Ti* | 16.2 ± 1.5 | 3.2 ± 0.2 | 1.4 ± 0.1 |
| Ag/Au/Ti | 18 ± 1.5 | 16 ± 1 | 13.2 ± 0.3 |
| Substrate | Deposition Conditions | Sample Series | ||||
|---|---|---|---|---|---|---|
| Precursor | Load (mg) | Temperature (°C) | Details | |||
| Tv | Td | |||||
| CFR-PEEK | Ag | 5 | 1300 | 150 | PVD UVM.71 installation, U = 400 V, I = 400 mA 8 × 10−7 Torr | Ag/CFR-PEEK |
| Ir/CFR-PEEK | Ag/Ir/CFR-PEEK | |||||
| Au/CFR-PEEK | Ag/Au/CFR-PEEK | |||||
| [Ag(cod)(hfac)]2 | 40 | 120 | 300 | MOCVD hand-made installation, v(Ar) = 9 L/h, v(H2) = 12 L/h, 5.7 Torr | ||
| Ir/Ti | Ag/Ir/Ti | |||||
| Ir/Ti* | Ag/Ir/Ti* | |||||
| Au/Ti | Ag/Au/Ti | |||||
| Method | Abbreviation | Equipment and Experimental Details | Interpretation |
|---|---|---|---|
| X-ray diffraction | XRD | Shimadzu XRD-7000 diffractometer, Shimadzu, Kyoto, Japan, CuKα radiation (2θ = 10–80°). | XRD patterns of Au/Ti and Au/CFR-PEEK samples were indexed according to the RDF-2 database (ICDD, Newtown Square, PA, USA) (version 2022). |
| Inductively coupled plasma atomic emission spectroscopy | ICP-OES | High-resolution spectrometer iCAP 6500 (Thermo Fisher Scientific, Waltham, MA USA). The registration of samples was performed at the axial observation of plasma: cooling argon flow was 12 L/min, secondary was 0.5 L/min, registration time was 5 s, power supplied to an ICP inductor was 1150 W. | The nitric acid solutions of as-deposited samples (Table 3, Column 7) and samples after 30 and 90 days of implantation were prepared using the standard procedure described in Ref. [25]. The Ag and Au contents were calculated using the most intense analytical lines: 208.209, 242.795, 267.595 nm for Au, and 328.068, 338.289 nm for Ag. |
| X-ray photoelectron spectroscopy | XPS | PHOIBOS-150 analyzer with 1D-DLD detector, FOCUS-500 monochromator (SPECS, Berlin, Germany), Al Kα radiation, hv = 1486.71 eV, 14 kV, 200 W). Calibration of binding energies by the Fermi level of the valence band (0.0 eV). | The spectra of Ag/Au/CFR-PEEK, Ag/Ir/Ti, and Ag/Au/Ti samples were processed in the CASA program version 2.2 software (Tokyo, Japan) using the Voigt function. The background was taken into account using the Shirley method. For Ir, Au 4f peaks fitting, the parameters proposed by Pfeifer et al. were used [73]. |
| Atomic force microscopy | AFM | Microscope with a semi-contact mode with an Ntegra Prima II (NTMDT, Moscow, Russia): length was 123 µm, width was 34 µm, force constant was 17 N/m, and resonance frequency was 230 kHz. | The roughness parameters of bare Ti, Ti* substrates and samples (Table 3, Column 7) were calculated using the Nova SPM version 4.0 software 197374, St. Petersburg, Savushkina street, building 83 k3, office 236, Russia |
| Scanning Electron Microscopy | SEM | HITACHI UHR FE-SEM SU8200, Hitachi, Ltd., Hitachi, Japan | All samples (Table 3, Column 7) were scanned at the same conditions (3 keV, LA detector). SEM images of the samples (Tiff files) were imported into the program image analysis version 1.54 software (ImageJ) National Institutes of Health, 9000 Rockville Pike, Bethesda, Rockville, MA, USA (version 2.0.0) to study Ag particles size distribution in case of Ag/CFR-PEEK. |
| Energy-dispersive X-ray spectroscopy | EDX | EDX-analizator EX-2300BU connected with SEM, JEOL-ISM 6700 F microscope, Tokyo, Japan | EDX spectra of Ag/Ir/CFR-PEEK and Ag/Au/CFR-PEEK were recorded using Quantax 70 Bruker version 1.3 software, Schwazchid st. 12, Berlin, Germany |
Disclaimer/Publisher’s Note: The statements, opinions and data contained in all publications are solely those of the individual author(s) and contributor(s) and not of MDPI and/or the editor(s). MDPI and/or the editor(s) disclaim responsibility for any injury to people or property resulting from any ideas, methods, instructions or products referred to in the content. |
© 2024 by the authors. Licensee MDPI, Basel, Switzerland. This article is an open access article distributed under the terms and conditions of the Creative Commons Attribution (CC BY) license (https://creativecommons.org/licenses/by/4.0/).
Share and Cite
Sergeevichev, D.S.; Dorovskikh, S.I.; Vikulova, E.S.; Chepeleva, E.V.; Vasiliyeva, M.B.; Koretskaya, T.P.; Fedorenko, A.D.; Nasimov, D.A.; Guselnikova, T.Y.; Popovetsky, P.S.; et al. Vapor-Phase-Deposited Ag/Ir and Ag/Au Film Heterostructures for Implant Materials: Cytotoxic, Antibacterial and Histological Studies. Int. J. Mol. Sci. 2024, 25, 1100. https://doi.org/10.3390/ijms25021100
Sergeevichev DS, Dorovskikh SI, Vikulova ES, Chepeleva EV, Vasiliyeva MB, Koretskaya TP, Fedorenko AD, Nasimov DA, Guselnikova TY, Popovetsky PS, et al. Vapor-Phase-Deposited Ag/Ir and Ag/Au Film Heterostructures for Implant Materials: Cytotoxic, Antibacterial and Histological Studies. International Journal of Molecular Sciences. 2024; 25(2):1100. https://doi.org/10.3390/ijms25021100
Chicago/Turabian StyleSergeevichev, David S., Svetlana I. Dorovskikh, Evgeniia S. Vikulova, Elena V. Chepeleva, Maria B. Vasiliyeva, Tatiana P. Koretskaya, Anastasiya D. Fedorenko, Dmitriy A. Nasimov, Tatiana Y. Guselnikova, Pavel S. Popovetsky, and et al. 2024. "Vapor-Phase-Deposited Ag/Ir and Ag/Au Film Heterostructures for Implant Materials: Cytotoxic, Antibacterial and Histological Studies" International Journal of Molecular Sciences 25, no. 2: 1100. https://doi.org/10.3390/ijms25021100
APA StyleSergeevichev, D. S., Dorovskikh, S. I., Vikulova, E. S., Chepeleva, E. V., Vasiliyeva, M. B., Koretskaya, T. P., Fedorenko, A. D., Nasimov, D. A., Guselnikova, T. Y., Popovetsky, P. S., Morozova, N. B., & Basova, T. V. (2024). Vapor-Phase-Deposited Ag/Ir and Ag/Au Film Heterostructures for Implant Materials: Cytotoxic, Antibacterial and Histological Studies. International Journal of Molecular Sciences, 25(2), 1100. https://doi.org/10.3390/ijms25021100

